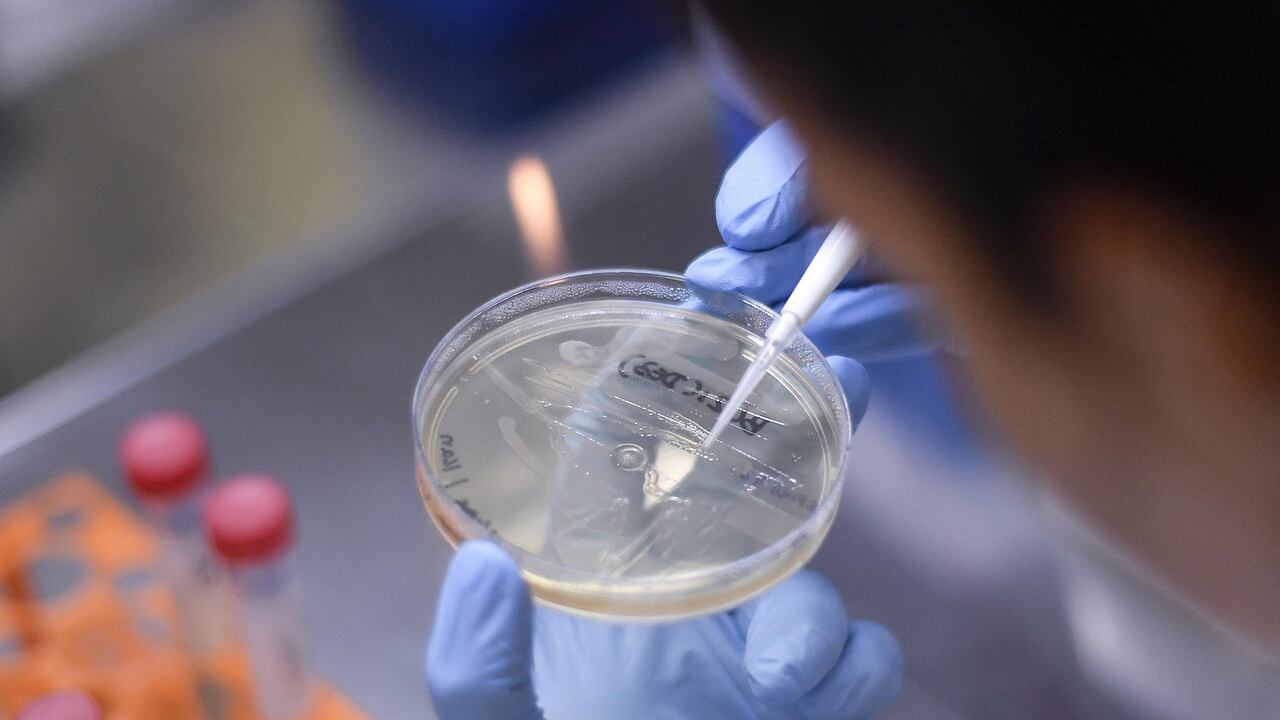

CANCILLERÍA COLOMBIA
Cancillería advierte que en la región hay riesgo de monopolios de vacuna para el covid-19
Dado que la mayoría de los estudios en el mundo son privados, la Cancillería de Colombia consideró que sí hay riesgo.
![]() Siga a EL PAÍS en Google Discover y no se pierda las últimas noticias
Siga a EL PAÍS en Google Discover y no se pierda las últimas noticias
13 de ago de 2020, 12:10 p. m.
Actualizado el 30 de dic de 2024, 11:18 p. m.
Noticias Destacadas
En respuesta al cuestionario del Congreso sobre la gestión en Colombia para garantizar el acceso a una eventual vacuna contra el covid-19, la Cancillería reconoció que a nivel mundial sí existe el riesgo de un monopolio.
"Teniendo en cuenta que en su gran mayoría los proyectos están siendo desarrollados por entidades privadas, tal riesgo está presente. Igualmente, hay que tener en consideración que muchas de estas farmacéuticas no tienen capacidad para producir vacunas a una escala que pueda satisfacer completamente la demanda mundial", advierten.
La cartera recordó que los gobiernos de algunos países han venido asegurando las primeras dosis para sus ciudadanos, aunque no existe ningún proyecto cuya eficacia esté aprobada por la Organización Mundial de la Salud, OMS.
Actualmente se tiene conocimiento de 30 investigaciones que llegaron a las fases avanzadas, y alrededor de 140 en etapas tempranas, cifra que disminuye el riesgo de acaparamiento o monopolio.
La Cancillería también indicó que a través del Fondo de Acceso Global para las Vacunas, Covax, Colombia se beneficiaría con suficientes dosis de vacunas para inmunizar al 20 % de la población en primera instancia.
Por su parte, el Ministerio de Salud ha advertido que no será posible adquirir la vacuna Sputnik V, registrada por Rusia en medio del escepticismo de la comunidad científica, hasta que los productores no revelen información detallada que permita a las autoridades competentes evaluar los estándares de seguridad globales.
Lea además: Capturan padre e hijo que estafaban con 'pócima milagrosa' para covid-19

 6024455000
6024455000







